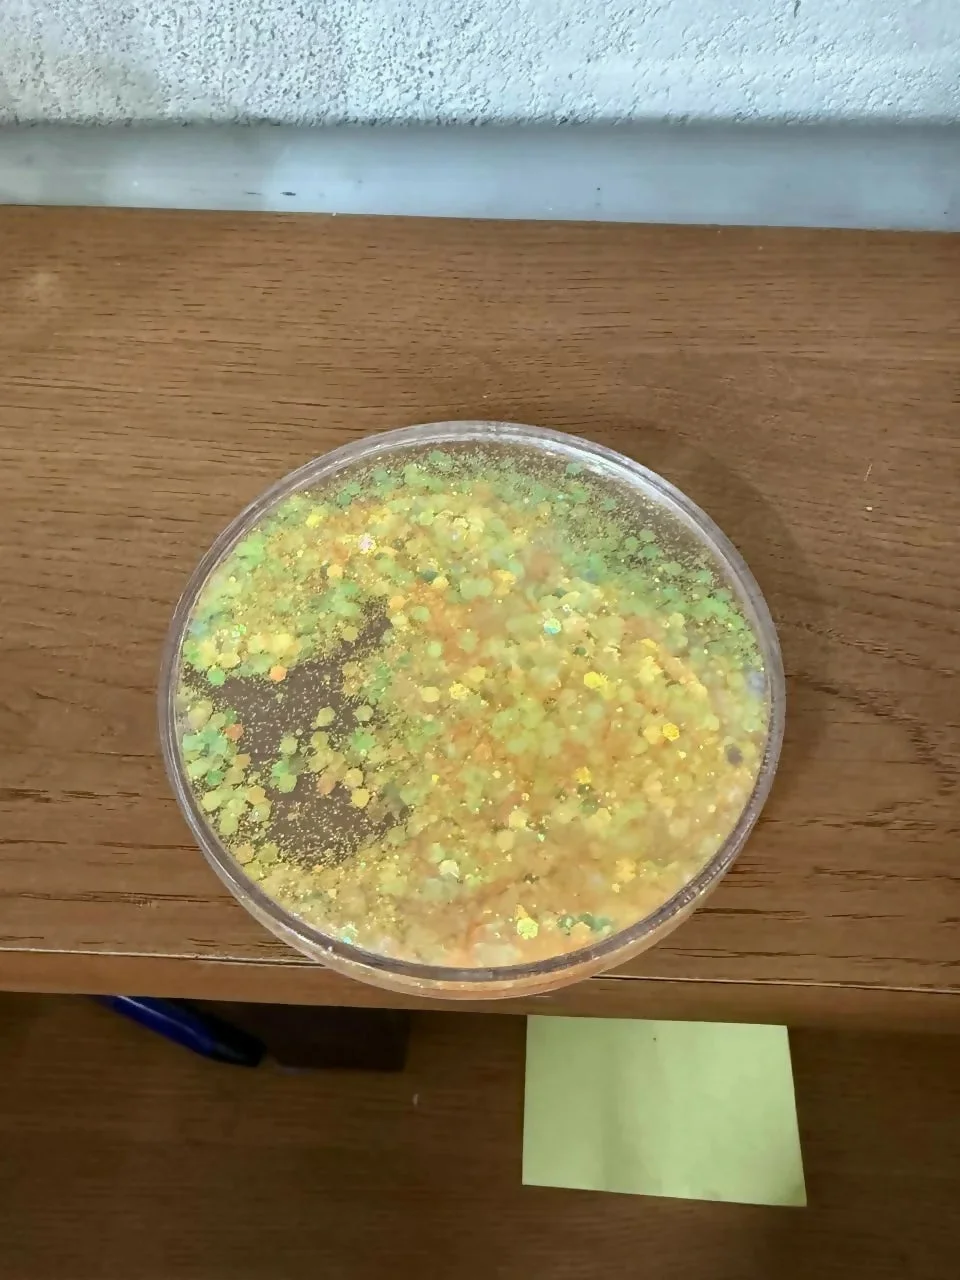

Free shipping on orders above Rs.999!

Free Shipping
Above ₹999
100% Genuine
Authentic
Easy Returns
7-day policy
Fast Delivery
2–5 business days
Add a touch of sparkle and functionality to your daily routine with this glitter resin cup lid and coaster set. Designed to keep your beverages protected while enhancing your table décor, this set combines style with practicality. The shimmering resin surface not only looks attractive but also helps prevent dust from entering your drink. Ideal for home, office, or gifting, it fits most standard mugs and adds a decorative charm to any space.
Key Features:
• Multipurpose Design – Works as both cup lid and coaster
• Glitter Resin Finish – Stylish and eye-catching sparkle effect
• Dust Protection – Helps keep drinks clean and covered
• Durable Material – Strong and long-lasting resin build
• Easy to Clean – Smooth surface for quick cleaning
• Universal Fit – Suitable for most standard mugs and cups
• Ideal Gift Option – Great for home, office, or special occasions
cup lid, mug cover, resin coaster, glitter coaster, drink cover, cup accessory, table coaster, mug lid cover, decorative coaster, kitchen accessory, office desk item, reusable coaster, cup protector, stylish coaster set
Be the first to review Yellow Glitter Resin Cup Lid and Coaster Set for Mug Cover!
No account needed — verify with OTP
0/1000
We'll verify your identity with a quick OTP
You might also like
₹54
Save ₹54